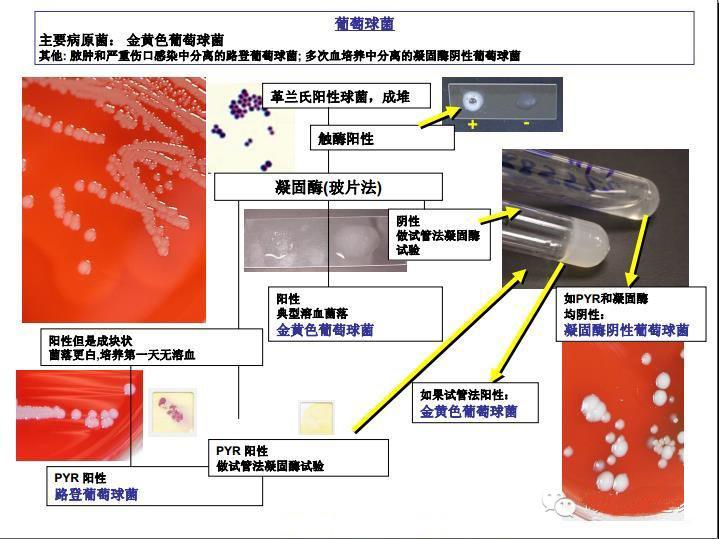

摘要:本文介绍了微生物检测的最新步骤指南。通过遵循一系列严格的实验室操作程序,包括样品采集、处理、培养和鉴定等步骤,可以确保准确、可靠地检测微生物。本文提供了有关微生物检测的最新技术和方法,以帮助实验室人员更好地理解和执行微生物检测,从而保障公共卫生和食品安全。摘要字数在100-200字之间。
微生物检测作为研究和监测微生物的重要手段,对于保障食品安全、环境监测以及医疗诊断等领域具有至关重要的作用,本文将为您详细介绍微生物检测的最新步骤,内容涵盖从准备阶段到实验操作步骤、数据解析与报告撰写等各个方面,旨在帮助初学者快速入门,同时让进阶用户了解最新的技术动态。
准备阶段
1、了解基础知识:掌握微生物学的基本概念、微生物的分类、生长条件及代谢特点等基础知识。
2、准备实验环境:确保实验环境符合微生物检测标准,包括洁净的实验台、无菌室或生物安全柜等。
3、准备试剂与器材:根据实验需求准备相应的培养基、试剂、仪器等,如显微镜、高压蒸汽灭菌器、恒温培养箱等。
样品处理
1、样品采集:按照实验需求采集具有代表性的样品,如食品、水源、土壤等,并遵循无菌操作原则。
2、样品预处理:对采集的样品进行适当处理,以便后续检测,固体样品可能需要研磨、过滤等;液体样品则可能需要离心、稀释等。
微生物检测最新技术介绍
1、宏基因组学:通过测序和分析环境样本中的全部微生物基因,了解微生物群落结构、功能及其与环境的关系。
2、生物传感器:利用生物传感器技术快速、灵敏、准确地检测细菌、病毒等微生物。
3、实时荧光定量PCR(RT-PCR):定量检测特定微生物的基因表达水平,具有高度的特异性和灵敏度。
实验操作步骤
1、无菌操作:在无菌环境下进行样品、试剂、器材等的操作,以避免微生物污染。
2、培养基的制备:根据实验需求制备相应的培养基。
3、接种与培养:将处理后的样品接种于培养基上,并在适宜条件下进行培养。
4、观察与记录:对培养过程中的微生物进行观察,并记录其生长情况、形态特征等。
5、结果分析:根据观察结果进行分析,判断微生物的种类、数量等,结合实验目的得出实验结论。
数据解析与报告撰写
1、数据解析:对实验数据进行解析,包括微生物数量、种类、分布等,并结合实验目的和背景进行分析。
2、报告撰写:撰写包含实验目的、方法、结果、讨论等部分的实验报告,确保报告内容准确、完整、条理清晰。
注意事项
1、严格遵守无菌操作原则,避免微生物污染。
2、注意实验室安全,避免发生意外事故。
3、不断学习新知识,关注微生物检测最新技术动态,提高实验技能。
通过本文的学习,读者可以快速掌握微生物检测的基本技能,了解最新技术动态,在实际操作中,要严格遵守操作规程,确保实验结果的准确性,希望本文能为您的微生物检测工作提供有益的参考和指导。

京公网安备11000000000001号
京公网安备11000000000001号 京ICP备11000001号
京ICP备11000001号
还没有评论,来说两句吧...